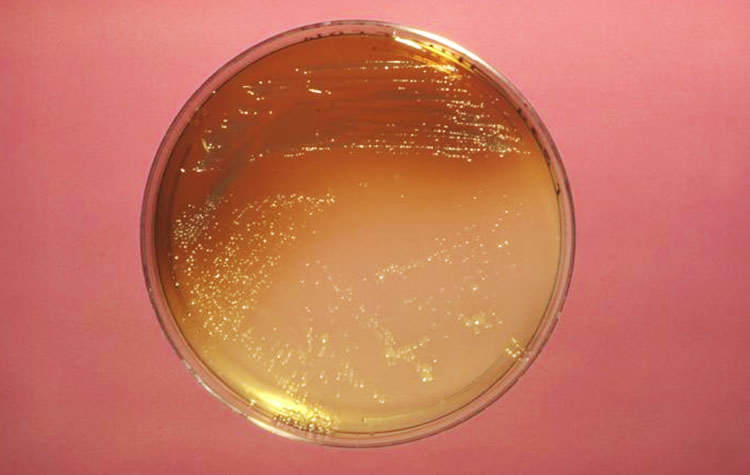
Técnicas rápidas de detección de Legionella, una necesidad para la prevención eficiente

Las nuevas técnicas rápidas para la detección de la Legionella proporcionan una información analítica rápida, oportuna y útil para potenciar la toma de decisiones que minimicen los escenarios de riesgo para la salud pública. Asi lo explicó Guillermo Rodríguez Albalat, director de I+D+i en Biótica, en el XV Congreso de Salud Ambiental.
La prevención y el control de la legionelosis fue uno de los temas desarrollados el pasado mes de mayo en el XV Congreso de Salud Ambiental, organizado por la Sociedad Española de Sanidad Ambiental (SESA). La participación de Guillermo Rodríguez Albalat, Director de I+D+i de la empresa de biotecnología Biótica, dibujó el panorama presente y futuro de las nuevas técnicas de detección rápida de la Legionella, como herramienta para la prevención efectiva de la legionelosis. Un enfoque que está alineado con los planes de prevención y control de Legionella (PPCL) recogidos en la norma UNE100030:2017 2 y que responde a una voluntad de compromiso con la protección de la salud de la comunidad.
A continuación destacamos algunos de los aspectos expuestos por Rodríguez Albalat en su interesante ponencia.
El valor de la prevención
La legionelosis sigue siendo una causa importante de morbilidad y mortalidad potencialmente prevenible en Europa. El calentamiento global y el envejecimiento de la población hacen prever un escenario dónde cada vez habrá más mayores que viven más tiempo, y que aumentan un segmento de población especialmente sensible a la Legionella. El incremento de usuarios en centros de día y residencias de personas mayores, asi como del turismo senior, requerirá optimizar las medidas preventivas y extremar las medidas de control para mejorar la protección de la salud de estas personas.
Lo mismo aplica a otros entornos donde puedan estar expuestas poblaciones de alto riesgo, como los hospitales, donde la Legionella es fatal en un 20-25% de los casos, y en lugares con tránsito frecuente de público, como hoteles, centros de ocio, oficinas, restaurantes, residencias, etc.
La ley (Real Decreto 865/2003) establece la responsabilidad para los titulares de las instalaciones susceptibles de proliferación y dispersión de Legionella de que se lleven a cabo las acciones necesarias para que éstas no representen un riesgo para la salud pública. Para ello, es fundamental que el titular disponga de la información necesaria para poder desplegar un plan eficiente de prevención y control de Legionella (PPCL), como los propuestos por el Comité Técnico de Normalización AENOR (CTN100 GT12) en el marco de la norma UNE100030:2017, documento complementario de referencia del RD 865/2003.
Esta norma, actualizada en 2017, introduce el concepto de Plan de Prevención y Control de Legionella (PPCL), como conjunto de actividades que permiten minimizar el riesgo de proliferación y/o dispersión de Legionella en las instalaciones, y que debe incluir un diagnóstico inicial, un programa de actuación, la evaluación periódica y si procede una auditoria externa. Asi pues, la prevención es un aspecto fundamental en el presente y en el futuro del control de la Legionella, que requiere de información analítica rápida y oportuna para ser realmente eficiente.
Limitaciones del cultivo en la prevención
La principal dificultad de añadir valor preventivo al PPCL con el método de cultivo es la demora entre la toma de muestra y la obtención del resultado (10-12 días), pero también la falta de garantía de recuento en todo el rango de detección.
Según Rodríguez Albalat, aunque fuera posible acortar el tiempo de ensayo, en las muestras ambientales, especialmente en las menos limpias, concurren otros factores que interfieren con la capacidad de Legionella para crecer en un medio de cultivo sólido. Entre ellos, los estados viables no cultivables (VBNC), microbiota que enmascare o inhiba la formación de colonias de Legionella, subestimando su concentración, o la liberación impredecible de células de Legionella por parte de amebas infectadas, sobrestimando su concentración.
Asi pues, existe un riesgo intrínseco en el método de cultivo de que el resultado final no refleje la situación de riesgo en el momento en que se tomó la muestra, ni el estado en que se encontraba la muestra en el momento en que se tomó. Las nuevas técnicas proporcionan una información más ajustada al estado de la bacteria en la instalación, y menos interferida por efectos que pueden desencadenarse de forma impredecible durante el proceso analítico clásico, desplegando la función preventiva sin oponerse al propósito original del método de cultivo: el aislamiento de una colonia que, en situación de brote, proporcione material para establecer una relación causa-efecto.
Sin embargo, esta relación causa-efecto nunca llega a establecerse en más de la mitad de los brotes. Es decir, que el coste de la investigación ambiental, microbiológica y epidemiológica asociada a un brote no alcanza su objetivo en más de la mitad de las ocasiones, con un coste medio para la administración de entre 450 000-760 000 €, y un coste de parada por instalación que, según su tipología, varía entre 3750-15 000 €/hora.
Por otra parte, desde una óptica ambiental, las técnicas nuevas asumen el reto de reducir la cantidad de residuo infectivo generado por el ensayo de Legionella. Un laboratorio que realice 5000 ensayos de cultivo de Legionella al año, generará como mínimo 1 638 000 gramos de residuo infectivo (más de
tonelada y media), y asume un coste medio de 1,4-1,6 €/ Kg de residuo.
Potenciar la función preventiva
La Norma UNE100030:2017 reconoce tanto el importante rol de las técnicas nuevas de Legionella para contribuir a un plan de prevención y control eficiente de la bacteria como la necesidad de mejorar estos planes, en un escenario en el que la legionelosis no ha dejado de crecer.
Con estas nuevas técnicas de detección, que deben estar validadas y certificadas, es posible acceder a la información oportuna para potenciar la función preventiva de la legionelosis. Sin embargo, esta información no está exenta de incertidumbre analítica, que el laboratorio debe acotar e interpretar, desde el conocimiento de la técnica, de la muestra y de la bacteria diana, y también el titular, desde el conocimiento de su instalación.
Rodríguez Albalat destaca la necesidad de que sean correctamente implementadas en laboratorios acreditados y de que éstos sean evaluados por organismos formados para ello, en un proceso colaborativo de construcción y mejora de la prevención de Legionella.
Las técnicas, validadas y certificadas, facilitan un compromiso entre la calidad de la determinación y los objetivos operativos. En general, las nuevas técnicas son métodos de análisis más “verdes” o “limpios”, y sus propiedades productivas (rapidez, bajos costes y riesgos) son ahora compatibles con las propiedades analíticas (exactitud, representatividad), lo que supone un nuevo paradigma en el control y vigilancia de la legionelosis.
En tanto que la información bioquímica de calidad va a permitir tomar decisiones correctas y a tiempo sobre cuando y como actuar en una instalación para prevenir la legionelosis, los métodos rápidos de detección validados y certificados, como son la separación inmunomagnética y la PCR, se muestran necesarios. Buscar los puntos de enriquecimiento mutuo entre técnicas y sus informaciones, más que enfatizar las que son aparentemente divergentes, es para este experto fundamental para el progreso científico y técnico de la instrumentación analítica en este sector.
Análisis on site
Por último, la ponencia de Rodríguez Albalat hace referencia a los análisis on site con sistemas autoanalizadores que generen los datos, que acumulan y envían a un centro de control. Esta es otra tendencia que se está imponiendo y a la que el marco regulatorio no podrá ignorar. En el ámbito de las instalaciones de riesgo, los sensores tienen un gran porvenir, no porque suministren datos, sino porque estos pueden tener mejor correspondencia con la realidad.
Estos sistemas proporcionarán una información rutinaria, en el mismo lenguaje que la generada por los laboratorios de rutina, a partir de la cual, y con nuevas tecnologías, tendrán la capacidad de construir la información requerida. El registro histórico, el análisis de tendencias, y la relación con otros parámetros físicos, químicos o microbiológicos, permitirá al usuario poder tomar decisiones fundamentadas, correctas y a tiempo.
Fuente: Necesidad, impulso y afianzamiento de nuevas técnicas de análisis de Legionella en la norma UNE100030:2017, Revista de Salud Ambiental